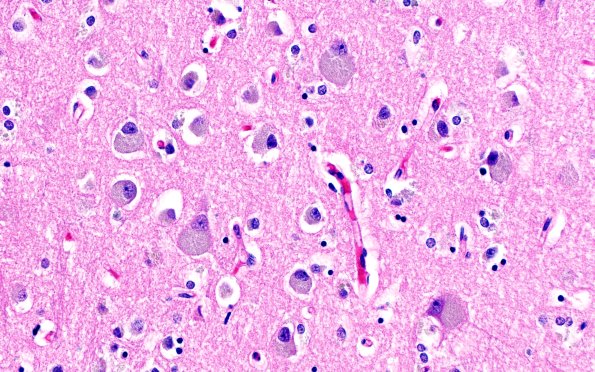
5B2 NCL (Case 5) L1B H&E 40X

Table of Contents
Washington University Experience | METABOLIC | Neuronal Ceroid Lipofuscinosis (NCL) | 5B2 NCL (Case 5) L1B H&E 40X
The frontal lobe cortex shown here exhibited dilatation of the pyramidal neurons by granular storage product, loss of neurons and astrocytosis. Cortical neurons, as well as those in other CNS sites, are engorged with orange, granular pigment; often nuclei are displaced into the proximal apical dendrite origin. (H&E)